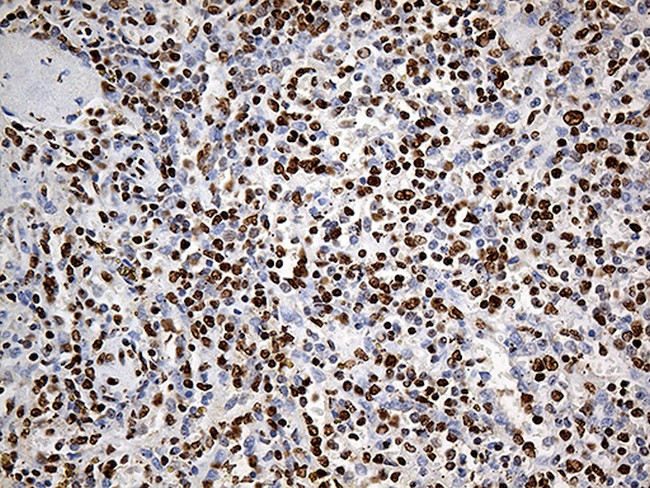
PTBP3 Antibody in Immunohistochemistry (Paraffin) (IHC (P))

Search
OriGene
PTBP3 Monoclonal Antibody (OTI5C9), TrueMAB™
{{$productOrderCtrl.translations['antibody.pdp.commerceCard.promotion.promotions']}}
{{$productOrderCtrl.translations['antibody.pdp.commerceCard.promotion.viewpromo']}}
{{$productOrderCtrl.translations['antibody.pdp.commerceCard.promotion.promocode']}}: {{promo.promoCode}} {{promo.promoTitle}} {{promo.promoDescription}}. {{$productOrderCtrl.translations['antibody.pdp.commerceCard.promotion.learnmore']}}
产品信息
TA812036
种属反应
宿主/亚型
分类
类型
克隆号
抗原
偶联物
形式
浓度
纯化类型
保存液
内含物
保存条件
运输条件
靶标信息
This gene is apparently required for both cerebellar and cortical development in humans. This gene mutations cause specific forms of Joubert syndrome-related disorders. Joubert syndrome (JS) is a recessively inherited developmental brain disorder with several identified causative chromosomal loci. Alternatively spliced transcript variants encoding different isoforms have been identified.
仅用于科研。不用于诊断过程。未经明确授权不得转售。
篇参考文献 (0)
生物信息学
蛋白别名: fission yeast differentiation regulator; Polypyrimidine tract-binding protein 3; Regulator of differentiation 1; Rod1; ROD1 regulator of differentiation 1
基因别名: PTBP3; ROD1
UniProt ID: (Human) O95758
Entrez Gene ID: (Human) 9991